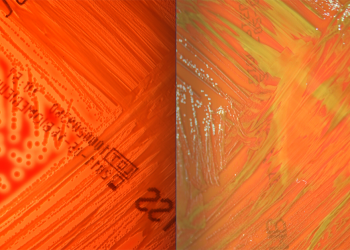

ΑΠΟ ΠΟΥ ΠΡΟΕΡΧΟΝΤΑΙ ΤΑ ΚΟΣΤΗ ΠΟΥ ΣΧΕΤΙΖΟΝΤΑΙ ΜΕ ΤΙΣ ΜΑΣΤΙΤΙΔΕΣ;
Λέγεται πάντα ότι η μαστίτιδα είναι η πιο ακριβή ασθένεια σε μια γαλακτοκοπαραγωγική εκτροφή. Ωστόσο, γνωρίζουμε πραγματικά τις οικονομικές επιπτώσεις της μαστίτιδας; Η επίγνωση του τι μας κοστίζει αυτή η...
Διαβάστε περισσότερα